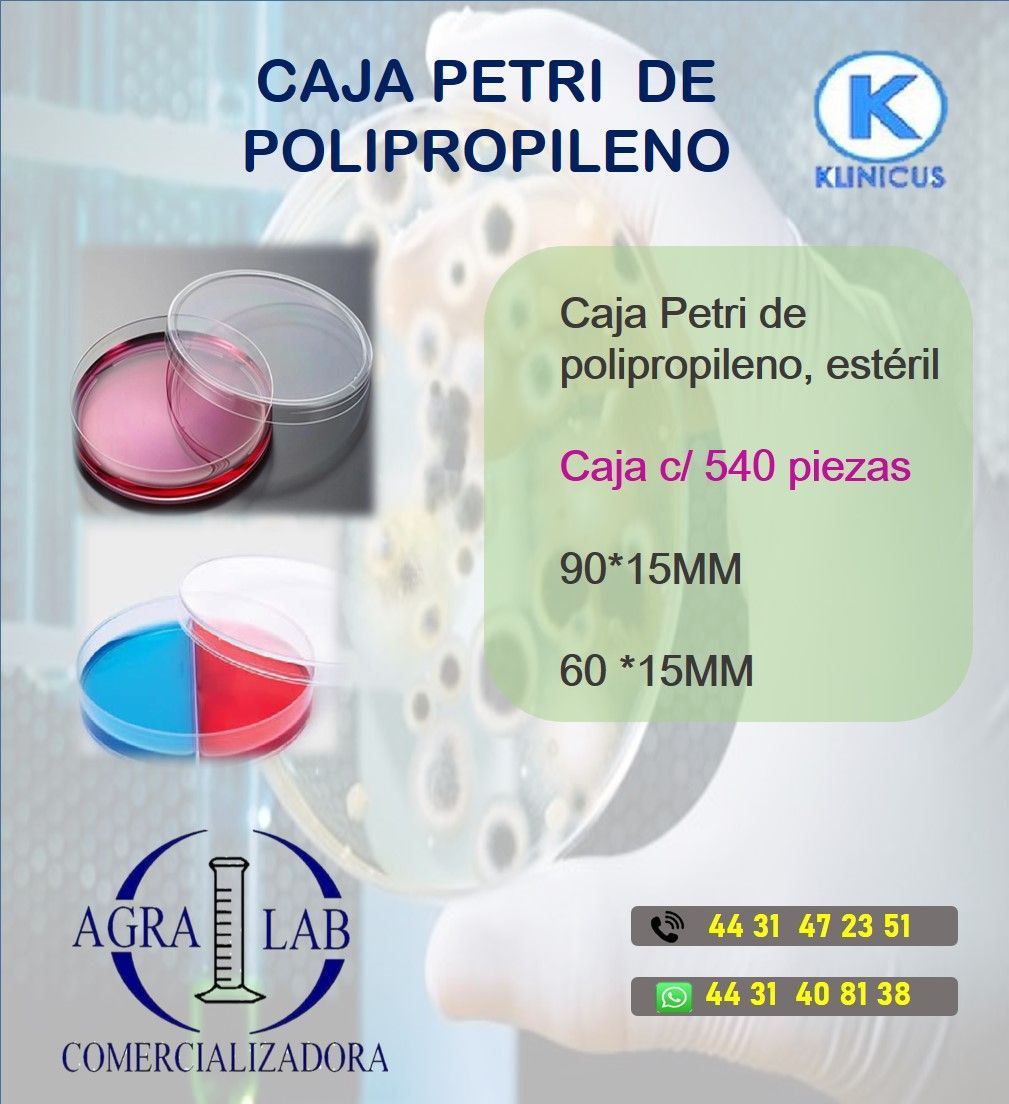

Reactivos químicos
HPLC
Equipo científico
Equipo clínico
Instrumentos para laboratorio
Placas Petrifilm
Medios de cultivo
Caja Petri
Cristalería para Laboratorio
Plásticos autoclavables
Agua destilada
Material de curación
Pruebas rápidas
Cristalería para laboratorio
Tubos de ensaye
Desecadores
Buretas
Condensadores
Vasos
Matraz
Pipetas
Cajas Petri
Adaptadores
Frascos GL45
Material clase A serializado y certificado
Botellas
Viales
Embudos
Densímetros
Equipo de extracción
Equipo de destilación
Goteros
Crisoles
Conectores
Termómetros
Cristalizador
Picnómetros
Material de Curación
Guantes
Cubrebocas
Recolectores RPBI
Abatelenguas
Aplicadores
Bolsas de orina
Cepillo Citologico
Espejo Vaginal
Lancetas
Algodon Torunda
Agua Oxigenada
Torniquetes
Curita Redondo
Batas para cirujano
Batas para paciente
Cofia